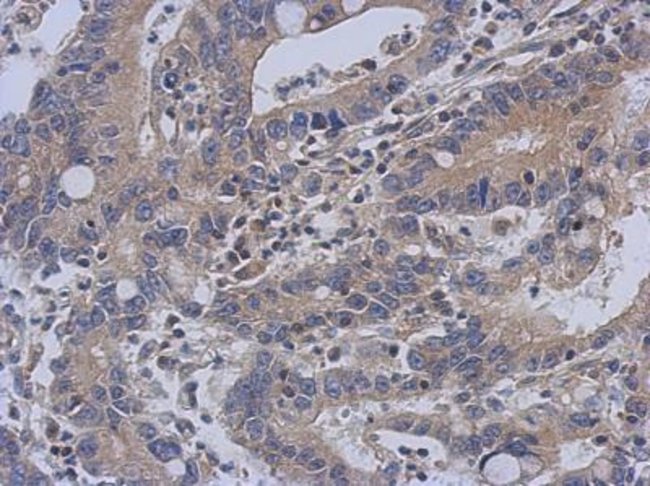

anti-NOP9, Polyclonal, Rabbit Polyclonal Antibody, Each
$ 748.31
|
|
Details:
NOP9 Polyclonal specifically detects NOP9 in Human samples. It is validated for Western Blot, Immunohistochemistry, Immunohistochemistry-Paraffin.
Additional Information
| SKU | 10447433 |
|---|---|
| UOM | Each |
| UNSPSC | 12352203 |
| Manufacturer Part Number | NBP215634 |

